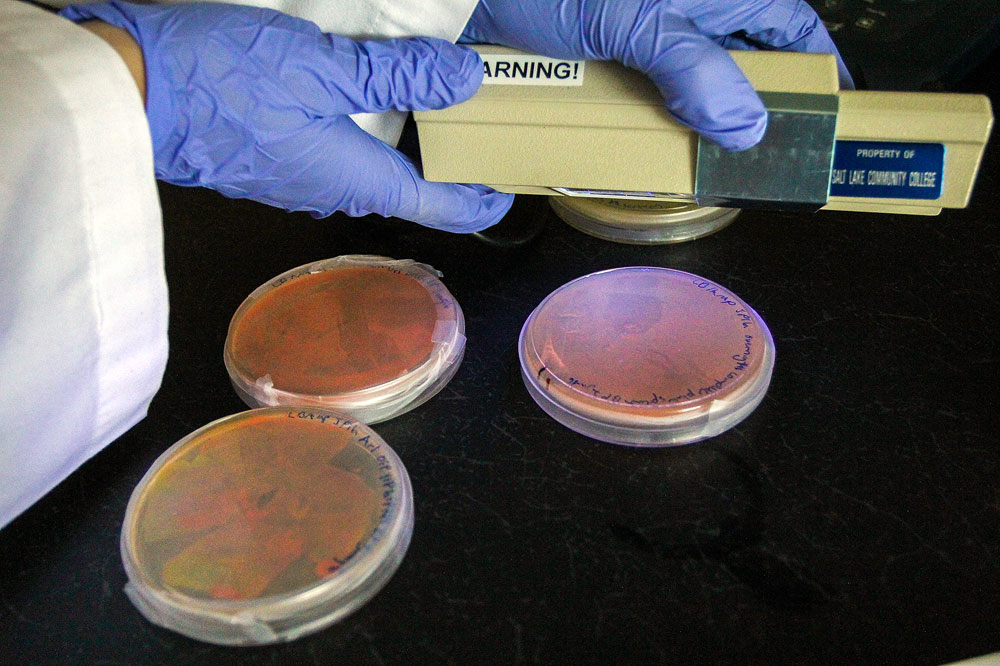
Biotech students conduct real-life research Ultraviolet testing

SLCCSA replaces fall concert with Bruin Bash
The Student Association moved the Bruin Bash to fall semester to increase student involvement.
Play pickup basketball at the LAC
The Staff Association invites all students and faculty to join the fun every Friday night.
Alternative Break: Why students should volunteer
Alternative Fall Break will take place next week. Learn more about the benefits of volunteering.
Library card opens doors to world of information
Students in Salt Lake County can access free databases and other services with a library card.
Xbox Wednesdays are back
Student Life and Leadership restarted the popular lunchtime activity this semester.
SLCC wants more women involved in aviation
The college hopes that more female students will consider a career in aviation.
SLCC hosting job fair today at Redwood Campus
Students are invited to speak with hundreds of companies today at the fall semester job fair.
New lab focuses on perfecting presentations
SLCC has set up a free tutoring lab to help students strengthen their presentation skills.
Biotech students conduct real-life research
The SLCC biotechnology program offers a constantly evolving learning environment.
Professor doesn’t just teach history, he wears it
Henri Miller takes a unique approach to give his history students a different learning experience.
Practice these parking lot safety tips
SLCC has a low crime rate, but students and staff should stay alert in the parking lots.
SLCC bicycle registry gains traction
Learn how SLCC students can improve their odds of recovering a stolen bicycle.